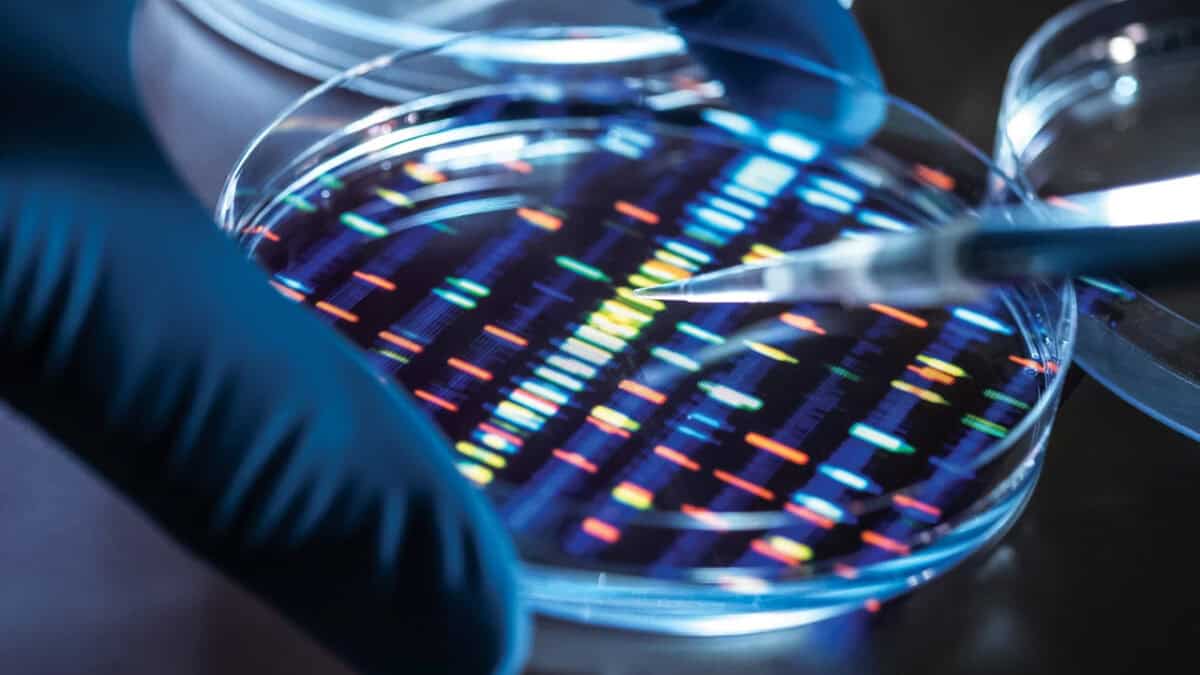

We are excited to share that Chemical & Engineering News has selected Light Horse Therapeutics® as one of its 10 Start-Ups to Watch. The article explores how our function-first discovery platform scans entire proteins with CRISPR base editing to pinpoint the amino acids that truly matter in disease biology, and how we then target those sites with our chemistry platform.
You can read the article here: https://cen.acs.org/pharmaceuticals/drug-discovery/Light-Horse-precision-cancer-drugs/103/web/2025/11.
We will continue advancing our internal programs while exploring partnerships that expand the impact of function-first discovery across oncology and beyond.
If you are interested in the science behind our approach or in partnering with Light Horse, explore the full profile at C&EN and get in touch with our team.